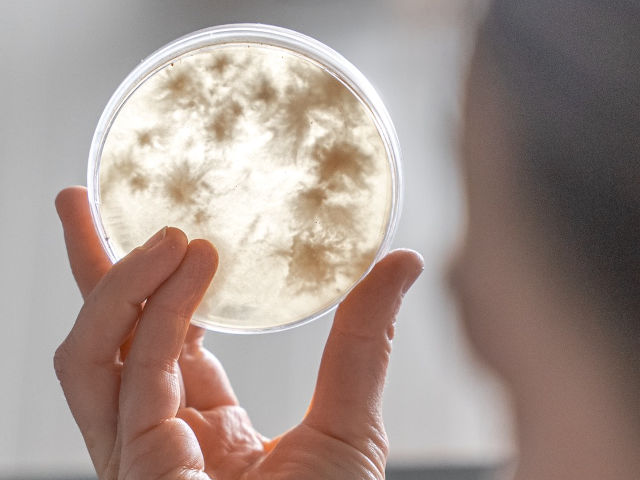

The growing concern over environmental sustainability has propelled the development of innovative eco friendly packaging solutions. Across the globe, from Green Technologies in the Netherlands to customised paper bags in the Netherlands, companies are devising revolutionary ways to reduce the carbon footprint of packaging. This narrative journey delves into the forefront of sustainable packaging innovations, casting a spotlight on the pioneering inventions driving change, like biodegradable packaging for businesses and the promise of biobags made from natural starch.

The Emergence of Mycelium Packaging
Standing at the vanguard of these advancements is mycelium packaging. Mycelium, the root structure of mushrooms, offers a highly sustainable alternative to traditional packaging. It’s not only biodegradable but also grows rapidly in just a few days, utilising agricultural by-products. Let’s explore the top five mycelium-based innovative eco friendly packaging companies making waves in the sector:
- Ecovative Design: Pioneers in using mycelium for eco-friendly packaging solutions in the Netherlands, they’ve set a standard for sustainability in the market.
- MOGU: Operating in Europe, MOGU focuses on crafting beautiful and functional mycelium products, including bespoke solutions for businesses.
- MycoWorks: Known for their innovative leather alternatives, they also produce packaging materials that are as durable as they are sustainable.
- Grown.bio: This brand offers customised mycelium packaging, catering to those in need of eco-friendly options for packaging electronics.
- Biohm: Encompassing a holistic approach, Biohm integrates mycelium into their product line tailored for environmentally conscious consumers.

An Edible Innovative Eco-Friendly Packaging
The journey of sustainable packaging wouldn’t be complete without mentioning the intriguing innovation of edible packaging. In the heart of developing this fantastic concept was a visionary company that sought to redefine how we view waste. Inspired by nature’s zero-waste philosophy, the company crafted a solution from seaweed and other natural ingredients. Originally seen as a whimsical idea, it found its footing when they partnered with major events, offering biodegradable and edible water packets to reduce plastic waste dramatically.

Challenges with Advanced Bioplastics
While the push to buy starch bags in wholesale has increased, advanced bioplastics face significant hurdles. Although these plastics are touted as sustainable, they can sometimes involve complex processing methods that require industrial settings to decompose effectively. This discrepancy places strain on consumers and businesses who wish to buy biodegradable bags in wholesale, expecting seamless breakdown in conventional environments.
The Role of AI in Smart Packaging
As technology advances, Artificial Intelligence (AI) is carving out a niche in smart innovative eco friendly packaging solutions. AI's capability to analyse consumer patterns allows for creating packaging designs that minimise waste. For example, real-time data analytics enable companies to optimise materials, reducing excess and tailoring customised paper bags in the Netherlands to meet exact consumer needs. This smart adaptation ensures eco-friendly packaging in the Netherlands remains a promising solution for reducing environmental impact.

From buying biodegradable packaging for businesses to exploring starch-based alternatives, the future of packaging is undeniably green. Through continuous innovation and awareness, we can transition towards a more sustainable world, one package at a time.





